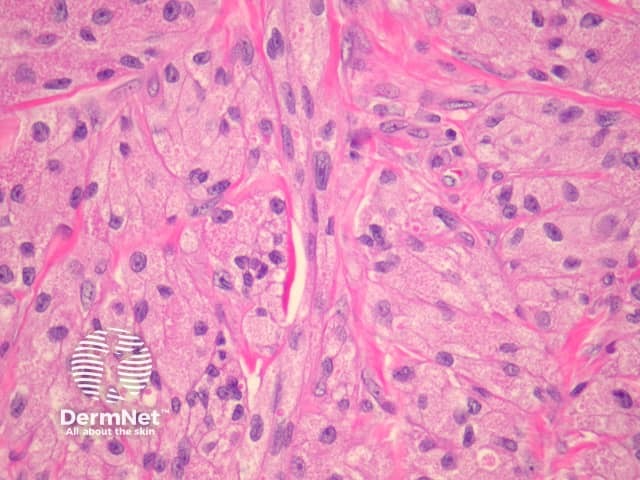
High power histopathology - demonstrates fine granularity of the tumour cytoplasm

Main menu
Common skin conditions
NEWS
Join DermNet PRO
Read more
Quick links
Authors: Dr Vera Miao, Northern Sydney; and Clinical Professor Saxon D Smith, Dermatologist, Sydney Adventist Hospital Clinical School, Australia (2023)
Previous contributors: Dr Todd Gunson, Dermatology Registrar (2008)
Reviewing dermatologist: Dr Ian Coulson
Edited by the DermNet content department
Introduction Demographics Causes Clinical features Variation of skin types Complications Diagnosis Differential diagnoses Treatment Outcome
Granular cell tumours are rare, generally benign, soft tissue neoplasms believed to originate from Schwann cells (cells that provide myelin insulation to nerves). They can occur in the skin, tongue, breast, gastrointestinal tract, and respiratory tract.
Granular cell tumours, also known as a granular cell myoblastoma or Abrikossoff tumour, display characteristic pathologic findings under the microscope. The vast majority of granular cell tumours are benign lesions; less than 2% are malignant.

Granular cell tumour on the wrist - the clinical diagnosis is seldom considered, and relies on histopathological assessment
High power histopathology - demonstrates fine granularity of the tumour cytoplasm
Granular cell tumours are rare and can occur in anyone. They tend to be more common in females and dark-skinned people. Most develop between the fourth to sixth decades of life.
Certain genetic mutations have been linked to granular cell tumours, although the exact mechanisms remain poorly understood.
In some case reports, multiple granular cell tumours have been associated with certain rare syndromes, including Leopard syndrome, Noonan syndrome, and neurofibromatosis type I.
Granular cell tumours may occur at any body site and are most commonly reported in the skin, tongue, breast, gastrointestinal tract, and respiratory tract. They occur in the skin or subcutaneous tissue in 30–40% of cases, most frequently on the head and neck.
Clinical features of a granular cell tumour include:
Multiple granular cell tumours may occur in up to 25% of cases.
Clinical features of a granular cell tumour that may suggest malignancy include:
Multiple granular cell tumours are more common in dark-skinned people. Lesions may vary in colour and have been described as white, grey, brown, or tan.
Diagnosis is made by skin biopsy. Excision biopsy is preferred to punch or shave biopsy. Histological features include characteristic granules within the cytoplasm of large tumour cells.